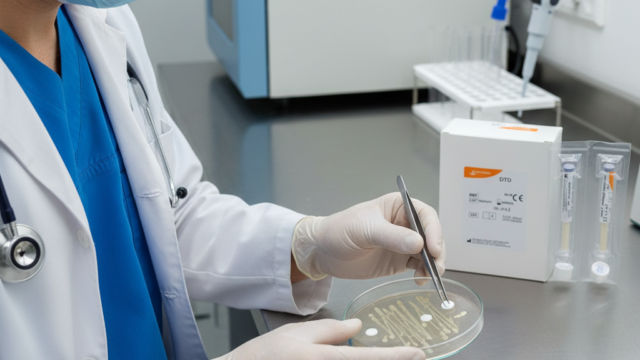

অ্যান্টিবায়োটিক ডিস্ক মাইক্রোবায়োলজি ল্যাবে একটি অপরিহার্য টুল, যা ব্যাকটেরিয়ার অ্যান্টিবায়োটিক সংবেদনশীলতা পরীক্ষার জন্য ব্যবহৃত হয়। এটি ছোট, ৬ মিমি ব্যাসের কাগজের ডিস্ক, যা নির্দিষ্ট পরিমাণ অ্যান্টিবায়োটিক দিয়ে গর্ভবতী করা হয়। বাংলাদেশে হাসপাতাল, ডায়াগনস্টিক সেন্টার, গবেষণাগার এবং শিক্ষা প্রতিষ্ঠানে এই ডিস্কের চাহিদা দিন দিন বাড়ছে। Kirby-Bauer ডিস্ক ডিফিউশন টেস্টের মাধ্যমে এটি ব্যাকটেরিয়ার বিরুদ্ধে কোন অ্যান্টিবায়োটিক কার্যকর তা নির্ধারণ করে।
কিন্তু বাংলাদেশে অ্যান্টিবায়োটিক ডিস্কের দাম কত? কোথায় পাওয়া যায়? কোন ব্র্যান্ড সেরা? এই ব্লগে আমরা ২০২৫ সালের সর্বশেষ তথ্যের ভিত্তিতে এই প্রশ্নগুলোর উত্তর দেব। SEO-অপটিমাইজড কীওয়ার্ড যেমন "অ্যান্টিবায়োটিক ডিস্ক দাম বাংলাদেশ" এবং "সস্তা ল্যাব ইকুইপমেন্ট" ব্যবহার করে আমরা দামের তুলনা, সাপ্লায়ার এবং কেনার টিপস নিয়ে আলোচনা করব। চলুন, বিস্তারিত জানা যাক! মেডিস্টোর বিডিতে এটি ৩৪০ টাকায় পাওয়া যায়, যা একটি সাশ্রয়ী অফার।
অ্যান্টিবায়োটিক ডিস্ক হলো ফিল্টার পেপারের তৈরি ছোট ডিস্ক, যা অ্যান্টিবায়োটিক (যেমন অ্যামপিসিলিন, টেট্রাসাইক্লিন) দিয়ে প্রি-ইমপ্রেগনেটেড। এটি মিউলার-হিন্টন আগারে রাখা হয়, যেখানে ব্যাকটেরিয়া কালচার করা হয়। ডিস্ক থেকে অ্যান্টিবায়োটিক ছড়িয়ে পড়ে এবং ব্যাকটেরিয়ার বৃদ্ধি বন্ধ করে, যার ফলে একটি ইনহিবিশন জোন তৈরি হয়। এই জোনের ব্যাস CLSI (Clinical and Laboratory Standards Institute) গাইডলাইনের সাথে তুলনা করে ফলাফল নির্ধারণ করা হয়।
কার্যপ্রণালী সংক্ষেপে:
ব্যাকটেরিয়া কালচার মিউলার-হিন্টন আগারে ছড়ানো হয়।
ডিস্ক প্লেটে রাখা হয় এবং ৩৫-৩৭°C তাপমাত্রায় ১৬-২৪ ঘণ্টা ইনকিউবেট করা হয়।
ইনহিবিশন জোন মাপা হয় এবং ফলাফল বিশ্লেষণ করা হয়।
এই পদ্ধতি সাশ্রয়ী, দ্রুত এবং বিশ্বব্যাপী গ্রহণযোগ্য। বাংলাদেশে এটি অ্যান্টিবায়োটিক রেজিস্ট্যান্স মোকাবিলায় গুরুত্বপূর্ণ।
বাংলাদেশে অ্যান্টিবায়োটিক ডিস্কের দাম ব্র্যান্ড, অ্যান্টিবায়োটিকের ধরন এবং প্যাক সাইজের উপর নির্ভর করে। সাধারণত ৫০ বা ১০০ ডিস্কের প্যাক পাওয়া যায়। ২০২৫ সালের আপডেট অনুযায়ী, নিচে জনপ্রিয় ব্র্যান্ডের দামের তালিকা দেওয়া হলো (সোর্স: Medistore BD, BMA Bazar, RTC Dhaka, Bdstall):
ব্র্যান্ড | ডিস্কের ধরন | প্যাক সাইজ | দাম (টাকা) | সাপ্লায়ার |
|---|---|---|---|---|
Oxoid | অ্যামপিসিলিন (১০ মাইক্রোগ্রাম) | ৫০ ডিস্ক | ২, ৫০০-৩, ৫০০ | Labtex BD, RTC Dhaka |
Amoxicillin 30 µg | সিপ্রোফ্লক্সাসিন (৫ মাইক্রোগ্রাম) | ৫০ডিস্ক | ৩৪০-৪৫০ | |
Bio-Rad | মাল্টি-ডিস্ক (৬টি অ্যান্টিবায়োটিক) | ৫০ ডিস্ক | ৪, ০০০-৫, ৫০০ | Lab Asia BD |
Oxoid | টেট্রাসাইক্লিন (৩০ মাইক্রোগ্রাম) | ১০০ ডিস্ক | ৪, ৫০০-৬, ০০০ | Labtex BD, Bdstall |
HiMedia | জেন্টামাইসিন (১০ মাইক্রোগ্রাম) | ৫০ ডিস্ক | ২, ২০০-৩, ২০০ | medistorebd, BMA Bazar, RTC Dhaka |
দামের ট্রেন্ড:
সিঙ্গল অ্যান্টিবায়োটিক ডিস্কের দাম ২, ০০০-৩, ৫০০ টাকা/৫০ ডিস্ক।
মাল্টি-ডিস্ক (৬-৮ অ্যান্টিবায়োটিক) ৪, ০০০-৬, ০০০ টাকা।
প্রমোশনে (যেমন medistorebd-তে) ১০-১৫% ছাড় পাওয়া যায়।
সেকেন্ড-হ্যান্ড বা বাল্ক ক্রয়ে দাম কমে (medistorebd-এ)।
মূল্য প্রভাবক ফ্যাক্টর:
ব্র্যান্ড: Oxoid এবং Bio-Rad দামি কিন্তু CLSI স্ট্যান্ডার্ড মেনে চলে। HiMedia সাশ্রয়ী।
ইমপোর্ট ডিউটি: ইউরোপ বা আমেরিকা থেকে আমদানি করা ডিস্কের দাম বেশি।
প্যাক সাইজ: ১০০ ডিস্কের প্যাক তুলনামূলকভাবে সাশ্রয়ী।
সাপ্লায়ার: অনলাইনে (medistorebd, Daraz, Bdstall) দাম কম, কিন্তু অফলাইনে সার্ভিস গ্যারান্টি ভালো।
বাংলাদেশে অ্যান্টিবায়োটিক ডিস্ক ঢাকা-কেন্দ্রিক সাপ্লায়ারদের মাধ্যমে সহজেই পাওয়া যায়। অনলাইন এবং অফলাইন উভয় অপশন রয়েছে। নিচে সেরা সাপ্লায়ারদের তালিকা:
অনলাইন vs অফলাইন: অনলাইনে দাম কম এবং ডেলিভারি সুবিধা রয়েছে। তবে ঢাকার মিরপুর বা গুলশানের ল্যাব সাপ্লাই শপে গিয়ে গুণগত মান চেক করে কেনা ভালো। চট্টগ্রাম বা সিলেটে Elite Trade BD থেকে ফ্রি ডেলিভারি পাওয়া যায়।
বাংলাদেশে অ্যান্টিবায়োটিক ডিস্কের জনপ্রিয় ব্র্যান্ডগুলো হলো:
Oxoid (UK):
সুবিধা: CLSI এবং EUCAST স্ট্যান্ডার্ড মেনে চলে, উচ্চ অ্যাকুরেসি, লং শেল্ফ লাইফ (১২-১৮ মাস)।
অসুবিধা: দাম বেশি (৩, ৫০০ টাকা/৫০ ডিস্ক)। স্টক সীমিত।
দাম: ২, ৫০০-৬, ০০০ টাকা।
HiMedia (India):
সুবিধা: সাশ্রয়ী, সহজলভ্য, ছোট ল্যাবের জন্য আদর্শ।
অসুবিধা: কিছু ক্ষেত্রে অ্যাকুরেসি সামান্য কম।
দাম: ২, ০০০-৩, ৫০০ টাকা।
Bio-Rad (USA):
সুবিধা: মাল্টি-ডিস্কে বৈচিত্র্য, গবেষণার জন্য উপযুক্ত।
অসুবিধা: দামি (৪, ৫০০+ টাকা), বড় ল্যাবের জন্য।
দাম: ৪, ০০০-৬, ০০০ টাকা।
টিপ: ছোট ল্যাবের জন্য HiMedia কিনুন, দাম কম এবং কোয়ালিটি ভালো। বড় হাসপাতালের জন্য Oxoid বা Bio-Rad বেছে নিন।
কম খরচে সেরা অ্যান্টিবায়োটিক ডিস্ক কেনার জন্য এই টিপস ফলো করুন:
ব্র্যান্ড চেক করুন: Oxoid বা HiMedia CLSI স্ট্যান্ডার্ড মেনে চলে। নন-ব্র্যান্ডেড ডিস্ক এড়িয়ে চলুন।
মেয়াদোত্তীর্ণ তারিখ: ডিস্কের শেল্ফ লাইফ ১২-১৮ মাস। কেনার আগে মেয়াদ চেক করুন।
স্টোরেজ কন্ডিশন: ২-৮°C তাপমাত্রায় স্টোর করা ডিস্ক কিনুন। ফ্রিজে রাখার ব্যবস্থা থাকলে ভালো।
প্যাক সাইজ: ছোট ল্যাবের জন্য ৫০ ডিস্কের প্যাক, বড় ল্যাবের জন্য ১০০ ডিস্কের প্যাক সাশ্রয়ী।
সাপ্লায়ারের বিশ্বাসযোগ্যতা: Labtex BD বা RTC Dhaka-এর মতো অথেনটিক সেলার থেকে কিনুন। অনলাইনে রিভিউ পড়ুন।
বাজেট: ২, ০০০-৪, ০০০ টাকার মধ্যে থাকুন। প্রমোশনে ছাড় নিন।
CLSI কমপ্লায়েন্স: ডিস্কে CLSI সার্টিফিকেশন আছে কিনা চেক করুন।
সাধারণ ভুল এড়ান: সস্তা নন-স্ট্যান্ডার্ড ডিস্ক কিনবেন না, এতে ফলাফল ভুল হতে পারে। সর্বদা মেয়াদ এবং স্টোরেজ কন্ডিশন চেক করুন।
ব্যবহারের নিয়ম:
মিউলার-হিন্টন আগারে ০.৫ ম্যাকফারল্যান্ড স্ট্যান্ডার্ড ব্যাকটেরিয়া কালচার তৈরি করুন।
ডিস্ক ২৪ মিমি দূরত্বে রাখুন এবং ৩৫-৩৭°C তাপমাত্রায় ইনকিউবেট করুন।
জোন মাপার জন্য ক্যালিপার ব্যবহার করুন।
রক্ষণাবেক্ষণ:
ডিস্ক ফ্রিজে (২-৮°C) সংরক্ষণ করুন।
আর্দ্রতা থেকে দূরে রাখুন এবং সিল করা প্যাকেটে স্টোর করুন।
মেয়াদোত্তীর্ণ ডিস্ক ব্যবহার করবেন না।
নিরাপত্তা: বায়োসেফটি ক্যাবিনেটে কাজ করুন এবং গ্লাভস ব্যবহার করুন।
ট্রাবলশুটিং: যদি জোন অস্পষ্ট হয়, তবে আগারের গভীরতা (৪ মিমি) এবং ইনকিউবেশন তাপমাত্রা চেক করুন। সাপ্লায়ারের সাথে যোগাযোগ করুন যদি ডিস্ক ত্রুটিপূর্ণ মনে হয়।
বাংলাদেশে অ্যান্টিবায়োটিক রেজিস্ট্যান্স একটি বড় সমস্যা। WHO-এর ২০২৫ রিপোর্ট অনুযায়ী, ৬৫% ব্যাকটেরিয়া স্ট্রেন কমপক্ষে একটি অ্যান্টিবায়োটিকের প্রতি প্রতিরোধী। অ্যান্টিবায়োটিক ডিস্ক টেস্ট রোগীর জন্য সঠিক চিকিৎসা নির্ধারণে সহায়ক। এটি হাসপাতালে সংক্রমণ নিয়ন্ত্রণ এবং গবেষণায় অবদান রাখে।
চাহিদার কারণ:
মেডিকেল সেক্টর: হাসপাতালে UTI, রক্ত সংক্রমণ ইত্যাদি পরীক্ষার জন্য।
গবেষণা: বিশ্ববিদ্যালয় এবং ফার্মাসিউটিক্যাল কোম্পানিতে রেজিস্ট্যান্স স্টাডি।
শিক্ষা: মাইক্রোবায়োলজি কোর্সে শিক্ষার্থীদের প্রশিক্ষণ।
বাংলাদেশে অ্যান্টিবায়োটিক ডিস্কের দাম ২, ০০০ টাকা থেকে শুরু, যা ছোট ল্যাবের জন্য সাশ্রয়ী। Oxoid, HiMedia এবং Bio-Rad ব্র্যান্ডগুলো নির্ভরযোগ্য এবং CLSI স্ট্যান্ডার্ড মেনে চলে। medistorebd, Labtex BD, BMA Bazar বা RTC Dhaka থেকে কিনুন এবং প্রমোশনে ছাড় নিন। সঠিক স্টোরেজ এবং ব্যবহারে এই ডিস্ক ল্যাবের কার্যকারিতা বাড়ায়। আরও তথ্য চাইলে techtunes.io-তে টিউমেন্ট করুন বা সাপ্লায়ারের সাথে যোগাযোগ করুন!
Oxoid এবং Bio-Rad CLSI স্ট্যান্ডার্ড মেনে চলে এবং অ্যাকুরেট। HiMedia সাশ্রয়ী এবং ছোট ল্যাবের জন্য ভালো।
medistorebd, Labtex BD, BMA Bazar, RTC Dhaka বা Bdstall-এ অনলাইন/অফলাইন কিনুন। ঢাকার মিরপুর বা গুলশানের শপে পাওয়া যায়।
২-৮°C তাপমাত্রায় ফ্রিজে সিল করা প্যাকেটে রাখুন। আর্দ্রতা থেকে দূরে রাখুন এবং মেয়াদ চেক করুন।
মিউলার-হিন্টন আগারে ব্যাকটেরিয়া কালচার করুন, ডিস্ক রাখুন, ৩৫-৩৭°C তাপমাত্রায় ১৬-২৪ ঘণ্টা ইনকিউবেট করুন এবং জোন মাপুন।
এটি ব্যাকটেরিয়ার সংবেদনশীলতা পরীক্ষা করে সঠিক চিকিৎসা নির্ধারণে সহায়ক এবং অ্যান্টিবায়োটিক রেজিস্ট্যান্স মোকাবিলায় কার্যকর।
আমি মেডিস্টোর বিডি। বিশ্বের সর্ববৃহৎ বিজ্ঞান ও প্রযুক্তির সৌশল নেটওয়ার্ক - টেকটিউনস এ আমি 8 মাস 3 সপ্তাহ যাবৎ যুক্ত আছি। টেকটিউনস আমি এ পর্যন্ত 40 টি টিউন ও 0 টি টিউমেন্ট করেছি। টেকটিউনসে আমার 1 ফলোয়ার আছে এবং আমি টেকটিউনসে 2 টিউনারকে ফলো করি।
medistorebd providing to you all kind of Healthcare, Baby Care, Medical, Surgical, Diagnostic, First Aid and beauty care product all over in Bangladesh
আপনার পণ্য ও সেবার ডিজিটাল মার্কেটিং করুন টেকটিউনসের সুবিশাল ৫ কোটি এর সৌশল নেটওয়ার্কে।
Techtunes ADs এর মাধ্যমে টেকটিউনসে ডিজিটাল মার্কেটিং করুন ১০ ধরনের এডভার্টাইজমেন্ট অপশনের মাধ্যমে। দারুন Competitive প্রাইজে আপনার পণ্য, সেবা ও ব্র্যান্ডের বিজ্ঞাপণ দিন আর পান ৩০০% এর ও বেশি রেসপন্স।
টেকটিউনসে বিজ্ঞাপণ দিতে ক্লিক করুন।
সুলভ মূল্যের অসংখ্য এডভার্টাইজমেন্ট প্যাক থেকে বেছে নিন আপনারটি। আপনার পছন্দমত USD কারেন্সিতে পেপাল, ক্রেডিডকার্ড এর মাধ্যমে অথবা BDT কারেন্সিতে বিকাশ, নগদ, উপায়, রকেট, ব্যাংক ট্রান্সফার এর মাধ্যমে মাত্র একক্লিকে Techtunes AD এর এডভার্টাইজমেন্ট কিনতে ক্লিক করুন Techtunes Buy.
আপনার এই টিউনটি ‘টেকটিউনস স্পন্সরড টিউন’ হিসেবে প্রোমট করুন টেকটিউনস এর সুবিশাল ৫ কোটি+ কমিউনিটিতে এবং ৩০০% এরও বেশি রেসপন্স পান। টেকটিউনস স্পন্সরড টিউন কিনতে ক্লিক করুন এখানে।